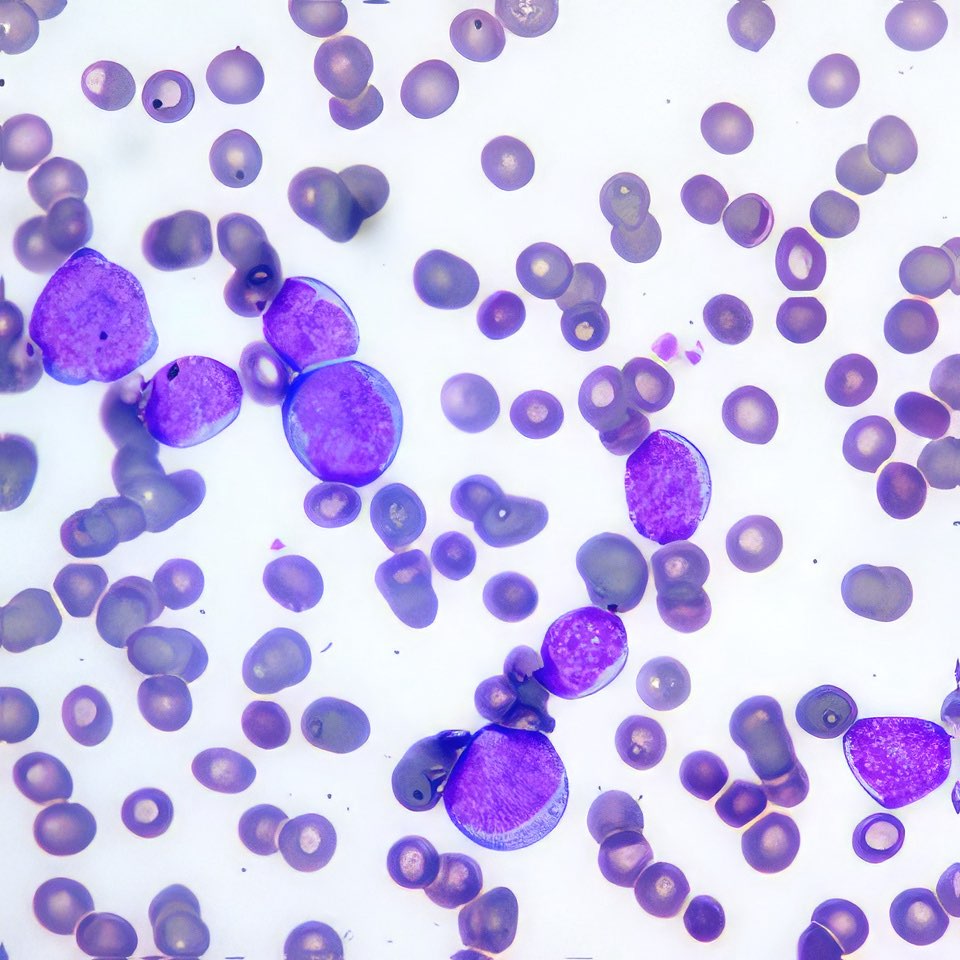
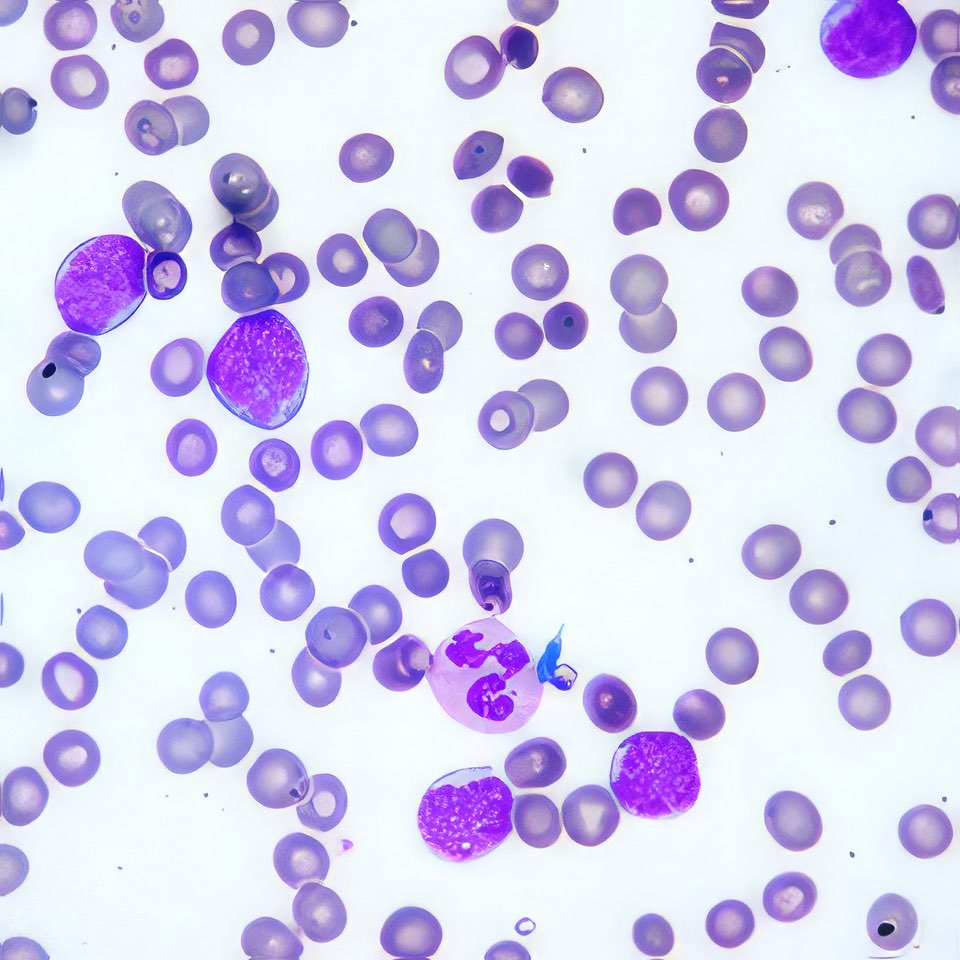

Zytologie global basiert hauptsächlich auf in Basel und Hamburg beobachteten Fällen, aber auch von Fällen, deren zytologische Bilder über das in Basel entwickelte iPath-Network aus anderen Teilen der Welt, insbesondere aus Mazzar-i-Scharif/Afghanistan übermittelt wurden.
Die Erfahrung mit letzteren Bildern zeigt zweierlei:
Zum einen führt die kontinuierliche telemedizinische Beratung mittels iPath von engagierten Kollegen in einem unterversorgten Land zur Verbesserung der diagnostischen Möglichkeiten.
Zum andern ist die Zytologie nicht nur eine patientenfreundliche Methode, sondern ermöglicht in diesen Ländern, mit geringem Aufwand und geringen Kosten rasch zu einer klinisch relevanten Diagnose zu kommen, auch wenn manche diagnostische Zusatzmethoden, die heute in entwickelteren Ländern zum Standard gehören, noch nicht zur Verfügung stehen.
Zytologie global soll Sie anregen, eigene diagnostische Überlegungen anzustellen, bevor Sie diese im nächsten Schritt abgleichen können.
Falldarstellungen
2/2026 > Mazzar-i-Scharif / Afghanistan
Klinische Angaben
45 Jahre w, Beidseitiger Milchfluss (Galaktorrhoe)
Abb. 1 - 4: Ausstrich von Milchröpfchen; H&E, A-C: origin. Obj. 40x,
Abb. 4: zusätzlich etwas vergrößert




Diagnose
Galactorrhoe
Beschreibung
Viele Makrophagen, darunter auch eine mehrkernige, mit fein-granulärem bis fein-vakuolärem Zytoplasma (Abb. 1-4). In Abb. 4 eine Gruppe von Epithelien mit uneinheitlich geformten hyperchromatischen Kernen und mehr grob-vakuolärem Zytoplasma. Der Ausstrichhintergrund enthält massenhaft bläschenartige Lipidtröpfchen.
Kommentar
Als Galaktorrhoe bezeichnet man Milchfluss außerhalb der Schwangerschaft und Stillperiode. Ursache ist eine erhöhte Prolaktinbildung in der Hypophyse. Sie kann durch einen Tumor von Hypophyse und Hypothalamus, aber auch durch verschiedene Medikamente (Antidepressiva, Antihypertonika, Antikoagulantien) und sogar durch ein Thoraxtrauma ausgelöst werden. Die Masse bläschenartiger Gebilde im Ausstrichhintergrund entsprechen durch die Alkoholfixation aufgelösten Lipidtröpfchen, die feinen Granula im Zytoplasma der Makrophagen Eiweißpartikeln der Milch. Beides, insbesondere die bläschenförmigen Gebilde, sind regelmäßig in der Stillphase nachweisbar. Die Epithelien in Abb. 4 sind wegen ihrer polymorphen Kerne besorgniserregend. Solche Zellen werden häufig auch in Feinnadelaspirationen von Brustveränderungen während der Laktationsphase gefunden und erfordern besonders bei Patientinnen im 4. Lebensjahrzehnt eine Ultraschalluntersuchung der Brust und klinische Kontrolle.
Literatur
- Sakiyama R, Quan M. (1983): Galactorrhea and hyperprolactinemia. Obstet Gynecol Surv.38:689-700
- Bruehlman RD, Winters S, McKittrick C. (2022): Galactorrhea: Rapid Evidence Review. Am Fam Physician. 106: 695-700.
- Schusterman MA, Bruce MK, Nicholas K et al. (2022): Galactorrhea After Nipple-Sparing Mastectomy: Case Report, Review of the Literature, and Algorithmic Approach to Management. Ann Plast Surg. 88: 467-469.
- Kameg BN, Wilson R (2022): Venlafaxine-related galactorrhea in an adolescent female: A case report. Arch Psychiatr Nurs. 40:106-108
1/2026 > Mazzar-i-Scharif / Afghanistan
Klinische Angaben
45 Jahre w, seit einem Jahr unregelmäßig begrenzter, 1,5 x 2,2 x
2,6 cm großer Knoten im oberen äußeren Quadranten der rechten
Brust.
Abbildung 1 – 4: HE-Färbung; 1 – 4, original Obj. 40x, Abb. 4:
zusätzlich vergrößert




Diagnose
Invasive breast carcinoma (IBC NST G3)
Beschreibung
Die sich teils überlagernden Zellen erscheinen meist nacktkernig oder haben nur wenig Zytoplasma. Die Kerne variieren deutlich in Form und Größe, sind grob strukturiert und zeigen vereinzelt kleine Chromozentren und Protrusionen. Im Hintergrund etwas Zelldetritus.
Histologie
Die histologischen Bilder (Abb. 1 und 2) bestätigen die zytologische Diagnose. Weite Teile des Gewebes sind durchsetzt von Tumorzellen, die nur angedeutet Verbände bilden und deutlich polymorphe Kerne aufweisen.
Kommentar
In diesem Fall bestand schon bei der klinischen Untersuchung kein Zweifel an der Karzinomdiagnose wegen eingezogener Brustwarze, oranger Hautfärbung und vergrößertem axillärem Lymphknoten, was klinisch nach WHO-Klassifikation T4bN1 entspricht. Die zytologische Diagnose eines Mammakarzinoms ist nicht immer so einfach. Dies gilt vor allem für das gut differenzierte tubuläre Karzinom, bei dem Größe und Form der Zellen nur schwer von normalen Zellen zu unterscheiden sind 12. Ähnliches gilt für das lobuläre Karzinom, dessen Zellkerne auch nur wenig in Form und Größe variieren; das auffälligste zytologische Merkmal ist die auch im zytologischen Präparat teilweise nachweisbare Indianfile-artige Anordnung 3. Die Trefferquote professionell durchgeführter FNA liegt knapp über 90%. Mag auch die Trefferquote der Dicknadel-Biopsie noch um wenige Prozent höher sein 4, so bietet die FNA besonders in unterversorgten Ländern den Vorteil, dass die Herstellung der Präparate einfacher, billiger und weniger zeitaufwendig ist.
Abbildung 1 und 2: Histologische Bilder desselben Falles, HE-Färbung, Abb.1: Obj. 10x, Abb. 2: Obj. 20x
Bildnachweise
Abu Ali Ibn Sina-Hospital, Mazar-i Scharif, Afghanistan
Dr. Atiq Sediqi
-
Boppana S, Erroll M, Reiches E, Hoda SA (1996): Cytologic characteristics of tubulolobular carcinoma of the breast. Acta Cytol. 1996 May-Jun;40(3): 465-71 ↩
-
Rajesh L, Dey P, Joshi K (2003): Fine needle aspiration cytology of lobular breast carcinoma. Comparison with other breast lesions. Acta Cytol. 47:177-82 ↩
-
Mucha Dufloth R, Xavier-Júnior JC, Moraes Neto FA et al. (2015): Fine needle aspiration cytology of lobular breast carcinoma and its variants. Acta Cytol. 59: 37-42 ↩
-
Bukhari MH, Akhtar ZM (2009): Comparison of accuracy of diagnostic modalities for evaluation of breast cancer with review of literature. Diagn Cytopathol. 37: 416-24 ↩


4/2025 > Mazzar-i-Scharif / Afghanistan
Klinische Angaben
30 Jahre w, Knoten im linken Schilddrüsenlappen,
Frischgewebsabstrich.
Abbildungen 2 - 4: Pap-Färbung, Obj. 40x.




Diagnose
Onkozytisches Adenom 1
Beschreibung
Die zytologischen Abb. 2-4 zeigen dieselben Zellen. Das Zytoplasma ist breit fragil und enthält massenhaft feine eosinophile Granula. Die relativ grob strukturierten Kerne variieren in Größe, sind aber einheitlich rund, zeigen keine Kerben und enthalten einen gut erkennbaren Nukleolus.
Kommentar
Die eosinophilen Granula im Zytoplasma der Zellen entsprechen einer
dichten Ansammlung von Mitochondrien und gleichen damit den das Hormon
Calcitonin produzierenden para-follikulären Zellen der Schilddrüse. Diese
onkozytischen Tumoren wurden früher als Hürthle-Zell-Tumoren
bezeichnet.
Es gibt eine gut- und eine bösartige Variante (Adenom und Karzinom), die
zytologisch meist nicht zu unterscheiden sind und nur die Diagnose
„follikuläre Neoplasie, Bethesda IV“ erlauben. Auch histologisch ist
die Unterscheidung oft schwierig.
Makroskopisch handelt es sich im vorliegenden Fall um einen etwas über
2 cm messenden, von einer dünnen Kapsel eingeschlossenen Tumor (Abb.
5). Zytologisch sind weder Mitosen noch Kernkerben nachweisbar.
Histologisch konnten weder ein Kapseleinbruch (Abb. 6 u. 7), noch eine
Gefäßinvasion, noch papilläre Strukturen nachgewiesen werden. Das sind
Hinweise auf mehrjährige Rezidivfreiheit.
Literatur
- Suster D, Craig Mackinnon A, Suster S (2023): Thyroid oncocytic (Hüthlt cell) nodules with longitudinal nuclear grooves: cninicopathologic, immunohistochemical, and molecular genetic study of 15 cases. Arch Pathol Lab Med 147: 684-691
- Stegenga MT, Oudijk L, van Velsen EFS et al (2025): Impact of reclassification of oncocytic and follicular thyoid carcinoma by the 2022 WHO classification. J Clin Endocrinol Metab 110: e1343-e1350
- Grusczczynski NR, Hasan SS, Brennan AG et al (2024): Oncocytic carcinoma of the thyroid: Cnclusions from a 20-year patient cohort. Head Neck 46, 2042-2047
-
iPath ID 1536749, Dr. Ataq Sediqi, Mazzari-Scharif/Afghanistan ↩



3/2025 > Mazzar-i-Scharif / Afghanistan
Klinische Angaben
Frau, 60 Jahre
Linkes Brustödem mit Veränderung der areolären Haut seit 3 Jahren,
axilläre Lymphadenopathie und linkes Handödem seit 2 Monaten.
(Abbildungen 3 - 6: Pap, Vergrößerung 1000x)






Diagnose
Morbus Paget
Beschreibung
Makroskopisch zeigt die areoläre Haut (Brustwarzenhof) eine feine ekzemartige nässende granuläre Struktur; die Brustwarze ist nicht eingezogen (Abb. 1 und 2). Die extrem atypischen Zellen liegen verstreut (Abb. 3), oder bilden lose zusammenhängende Gruppen (Abb. 4, 6). Einige sind doppelkernig. Im Vergleich zum gewöhnlichen Mammakarzinom sind sie extrem pleomorph und ihre Kerne sind stärker hyperchromatisch, sehr grob strukturiert, und zeigen manchmal prominente Chromozentren. Das Zytoplasma ist unterschiedlich breit und erscheint manchmal als vakuolär.
Histologie
Das durch Stanzbiopsie gewonnene histologische Präparat zeigt viele große, scheinbar vakuolisierte Zellen innerhalb des Plattenepithels. Eine PAS-Färbung war nicht möglich.
Differenzialdiagnose
Die zytologischen und histologischen Befunde sind charakteristisch für das Paget-Syndrom. Histologisch würden die Zellen PAS-positiv sein. Das Brustödem, die nicht eingezogene Brustwarze und die axilläre Schwellung weisen auf ein tiefsitzendes Karzinom hin, das bereits in die axillären Lymphknoten metastasiert hat. Die Kombination von Karzinom und Morbus Paget ist nicht ungewöhnlich 1. - Die extrem atypischen Zellen können zu einer Verwechslung mit einem Plattenepithelkarzinom führen 2. Andererseits unterscheidet dies die Zellen des Morbus Paget von denen des Adenoms, das ebenfalls in der areolären Region auftritt 3, 4. Schließlich können die makroskopisch erscheinenden vesikulären Strukturen einen Pemphigus vulgaris, eine Autoimmunerkrankung der Haut, simulieren 5.
-
Samarasinghe D(1), Frost F, Sterrett G, Whitaker D, Ingram D, Sheiner H. Cytological diagnosis of Paget’s disease of the nipple by scrape smears: a report of five cases. Diagn Cytopathol. 1993; 9(3): 291-5. ↩
-
Vohra P (1), Ljung BM, Miller TR, Hwang ES, van Zante A. Paget’s disease of the breast masquerading as squamous cell carcinoma on cytology: a case report. - Diagn Cytopathol. 2012; 40(11): 1015-8. ↩
-
Mazzara PF (1), Flint A, Naylor B. Adenoma of the nipple. Cytopathologic features. - Acta Cytol. 1989; 33(2): 188-90. ↩
-
Ozaki S(1), Mizukami Y(1), Kawahara E(1). Cytologic features of nipple adenoma: a report of four cases of adenoma of the nipple. - Diagn Cytopathol. 2015; 43(8): 664-8 ↩
-
Kobayashi TK (1), Ueda M, Nishino T, Kibe S, Higashida T, Watanabe S. Scrape cytology of pemphigus vulgaris of the nipple, a mimicker of Paget’s disease. Diagn Cytopathol. 1997; 16(2): 156-9. ↩


2/2025 > Zytologischen Abteilung der Pathologie am UKE Hamburg
Klinische Angaben
M, 68 Jahre, Urin aus der Neoblase
Abb. 1 - 4: Fremdkörper im Urinsediment, Pap, Abb. 2 u 4 bei polarisiertem
Licht;
ursprüngliche Vergrößerung 400x




Diagnose
Pflanzliche Zellen (Guarkernmehl)
Beschreibung
Abb. 1 und 2 zeigen in einem Haufen angeordnete Pflanzenzellen, Abb. 3 und 4 einzelne dieser Zellen bei etwas höherer Vergrößerung. Nur die relativ dicken kapselartigen Zellmembranen sind sichtbar, keine anderen Zellstrukturen. Im polarisierten Licht sind die Zellmembranen deutlich doppelbrechend (Abb. 2 und 4).
Kommentar
Guarkernmehl wird aus den Samen der Buschbohne (Cyamopsis tetragonoloba), einer in Südasien heimischen Gemüsepflanze, hergestellt. Das Mehl hat ein hohes Wasserbindevermögen und wird daher als Geliermittel in zahlreichen Lebensmitteln, aber auch medizinisch in Pulvern/Pudern als wasserbindender Zusatz verwendet. Im Fall des Patienten wurde es verwendet, um die Haut in der Umgebung des Urostmomas der Neoblase zu trocknen, damit der Harnkatheter und das Befestigungspflaster für den Urinbeutel besser halten. Von dort gelangten die Partikel in den Urin.
Differenzialdiagnose
Sehr ähnliche pflanzliche Partikel aus der Nahrung können auch in den Urin gelangen, wenn das Kolonkarzinom in die Harnblase eindringt. Dies zeigt, wie wichtig die klinischen Informationen sind.
Literatur
- Mudgil D, Barak S, Khatkar BS: Guar gum: processing, properties and food applications-A Review. J Food Sci Technol. 2014; 51(3): 409-18.
- Mondal A, Barai S, Bera H, Patel T, Sahoo NG, Begum D, Ghosh B: Ferulic acid-g-tamarind gum/guar gum based in situ gel-forming powders as wound dressings. Int J Biol Macromol. 2024; 277:134382.
1/2025 > Mazzar-i-Scharif / Afghanistan
Klinische Angaben
18 Jahre w, Infekt mit unklarem Ausgangsorgan: Lunge,
Urogenitaltrakt?
55 ml perikardiale Flüssigkeit; Pap; Original Obj. 40x



Diagnose
Granulozytose (ISRFC: Benigne)
Beschreibung
Ein besonderer Befund ist enge Anbindung von Neutrophilen an die sie vielfach phagozytierenden ein- oder mehrkernigen Makropgaben. - Auch in der Pleuraflüssigkeit wurde eine starke Zunahme an Neutrophilen festgestellt.
Bedeutung des Befundes
Grundsätzlich sind drei unterschiedliche Funktionen der Makrophagen zu unterscheiden:
- Abwehr von Krankheitserregern,
- Unterstützung der Wundheilung und
- Informationsbeschaffung innerhalb der generellen Immunabwehr.
Im vorliegenden Fall ist angesichts der klinischen Befunde, die für eine bakterielle Infektion sprechen, die Abwehr von Krankheitserregern anzunehmen. Es wird vermutet, dass die Phagozytose apototischer (durch „Selbstmord“ umgekommener) und nicht-apototischer Granulozyten und die Aufnahme von mikrobizidalen (Mikroben-schädlichen) Molekülen die Abwehr von Krankheitserregern unterstützt. Im vorliegenden Fall zeiget das besonders schön die enge Anbindung des Zytoplasmas der Granulozyten an das der Makrophagen.
Literatur
- Silva MT: Macrophage phagocytosis of neutropils inflammatory/infectious foci: a cooperative mechanism in the control of infection and infectious inflammation. - J Leuko Bill 2011: 89, 675-83
- Mosser DM, Edwards DP: Exploring the full spectrum of macrophage activation. NatRev Immune 2008; 12: 958-69
- Cole J, Aberdein J, Jubrail J, Dockrell DH: The role of macrophages in the innate immune response to Streptococcus pneumonia and Staphylococcus aureus: mechanisms and contrast. Adventskalender Micro Physical 2014; 65: 125-202
4/2024 > Mazzar-i-Scharif / Afghanistan
Klinische Angaben
M, 55 Jahre, bemerkte seit 3 Monaten eine zunehmende inguinale Lymphknotenschwellung, der größte 3 x 4 cm messend, davon Feinnadelaspiration (FNA). Abbildung 1 bis 4: Verschiedene Areale des zytologischen Ausstrichs. Orig. 63x




Diagnose
Metastase eine malignen Melanoms
Beschreibung
Die Bilder zeigen hochatypische Zellen. Deren überwiegend runde, teils auch ovalen Kerne variieren erheblich in ihrer Größe, sind deutlich grob strukturiert und enthalten meist ein oder mehrere prominente Nukleolen bzw. Chromozentren. Das Zytoplasma erscheint fragil. In jedem Bild finden sich auch Zellen mit pigmentbeladenem Zytoplasma. Der Ausstrichhintergrund enthält Blut und Zelldetritus, ebenfalls vermischt mit Pigmentkörnchen.
Kommentar
Der Patient beobachtete seit einem Jahr am Fuß eine pigmentierte Veränderung, die seit 3 Monaten auf 3 cm Durchmesser zunahm. Die prominente Atypie und die pigmenthaltigen Zellen sowie die ausgedehnte Metastasierung in die inguinalen Lymphknoten sind typisch für das Melanom. Eine Verwechslung des Melanin-Pigments mit Hämosiderin ist wegen der Zellatypie so gut wie ausgeschlossen. – Amelanotische Melanome zeigen oft eine weniger ausgeprägte Kernatypie und sind eher mit einem anderen Tumor zu verwechseln.
Bildnachweise
Abu Ali Ibn Sina-Hospital, Mazar-i Scharif, Afghanistan
Dr. Atiq Sediqi

3/2024 > Mazzar-i-Scharif / Afghanistan
Klinische Angaben
M, 8 Jahre alt, beidseitige Schwellung der Halslymphknoten, weiße Blutzellen 110’000, Lym 43.8%, Gran 23.5%, RBC 2.46, HB 8g/dl, PLT 30 000, CRP 96.

Diagnose
Akute lymphatische Leukämie (ALL)
Beschreibung
Die Bilder der Lymphknoten-FNA zeigen außer Blut nur kleine lymphozytäre, keine größeren follikuläre Zellen, wie bei einem Patienten in so jungem Alter zu erwarten. Die kleinen Zellen variieren erheblich in der Form und wenig in der Größe; einzelne von ihnen sind hantelförmig. Vereinzelt geschrumpfte strukturlose pyknotische Kerne (Abb. a li. oben). Die vitalen Zellen zeigen jedoch eine mehr oder weniger normale klumpige Chromatinstruktur (Abb. a, b). Infolge der Trocknung vor der Fixierung erscheinen die Giemsa-gefärbten Zellen im Blutausstrich viel größer, aber auch deutlicher polymorph (Abb. c, d).
Kommentar
Bis vor einigen Jahren wurde die FNA ausschließlich bei erwachsenen Patienten und nur selten bei Kindern angewendet {1}. Im vorliegenden Fall zeigen die ausgezeichneten Bilder, dass das Ergebnis von der Erfahrung des Arztes abhängt, der sie anwendet. Die durch die Pap-Färbung gut sichtbare Chromatinstruktur macht zusätzliche Tests zur Abgrenzung von anderen kleinzelligen Tumoren wie Ewing-Sarkom, Neuroblastom und Wilms-Tumor überflüssig. Die zytologische Diagnose wird durch die klinischen Daten gestützt. Die für die ALL typische Knochenmarksbeteiligung lässt sich an den klinischen Daten ablesen, d.h. an der niedrigen Zahl der roten Blutkörperchen (RBC) und der Blutplättchen sowie dem niedrigen Hämoglobinspiegel (HB). Etwa 80 % der ALL sind vom B-Zell-Typ. Ihre Entwicklung scheint von angeborenen DNA-Veränderungen abzuhängen. Wie in einer neueren Arbeit gezeigt wurde, sind Kinder mit Trisomie 21, der genetischen Ursache des Down-Syndroms, mit einem 20-fach erhöhten Risiko für ALL assoziiert {2}. Im Gegensatz zur ALL tritt die akute myeloische Leukämie (AML) nicht vor der Adoleszenz auf.
2/2024 > Mazzar-i-Scharif / Afghanistan
Klinische Angaben
M, 80 Jahre alt
Ulzerierte nasale Hautveränderung seit 8 Monaten, 3 x 2 cm im
Durchmesser, mit Hautödemen, Schmerzhaftigkeit.
Aus dem Krankenhaus Mazar-i-Scharif via iPath-Network übermittelte Bilder:




Diagnose
Plattenepithelkarzinom der Haut
Beschreibung
Einige lose Ansammlungen großer atypischer Zellen. Die Zellkerne variieren in der Größe, sind deutlich grob strukturiert und enthalten gelegentlich einen Nukleolus. Das Zytoplasma variiert in der Breite und ist manchmal geschwänzt. Der Hintergrund besteht aus Blut, einigen Entzündungszellen und Zelltrümmern.
Differenzialdiagnose
In der zytologischen Literatur gibt es zahlreiche Abhandlungen über die zytologische Diagnose von Hautläsionen. Die Informationen zur Materialentnahme reichen von Quetschungen, Abdrucken, Bürstenabstrichen bis hin zur FNA. Das Spektrum der Hautläsionen ist breit gefächert. Es reicht von Basalzellkarzinomen (BCC), Plattenepithelkarzinomen (SqCC), verschiedenen Haarfollikeltumoren bis hin zu Metastasen von Tumoren anderen Ursprungs {1-5}. Wegen der sich überschneidenden morphologischen Kriterien sind eine genaue Anamnese und Lokalisation sowie ein Makrofoto der Hautläsion hilfreich. Die histologische Diagnose lautete “keratinisierendes Plattenepithelkarzinom” (Abb. 5). Die keratinisierten Zellen waren zytologisch nicht nachweisbar. Allerdings sprechen die variable Kerngröße und das relativ breite Zytoplasma gegen ein BCC.
